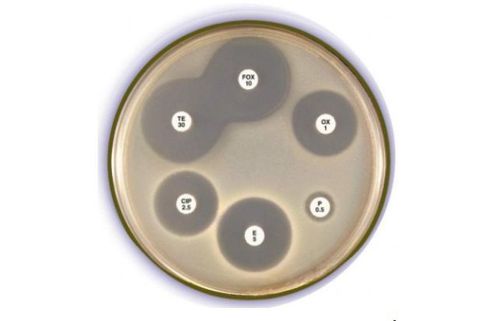

Kháng sinh đồ là một kỹ thuật đóng vai trò quan trọng trong việc hạn chế sự kháng thuốc của vi khuẩn, đồng thời phát hiện sự đề kháng kháng sinh của vi khuẩn thử nghiệm.
Khi khoa học phát triển mạnh mẽ đã có rất nhiều phương pháp kháng sinh đồ hiện đại và có độ chính xác cao.
Đối tượng nào thực hiện kháng sinh đồ
Khi bệnh nhân xuất hiện triệu chứng nghi ngờ là nhiễm khuẩn và có nguy cơ kháng lại thuốc kháng sinh thì bác sĩ sẽ chỉ định thực hiện kháng sinh đồ.

Nhiều trường hợp bệnh nhân sốt, hoặc gặp các triệu chứng nhiễm khuẩn và chưa sử dụng kháng sinh khi mới nhập viện nên thực hiện kháng sinh đồ để đạt được hiệu quả cao nhất.
Ý nghĩa của thực hiện kháng sinh đồ
Việc thực hiện kháng sinh đồ giúp định danh chính xác loại vi khuẩn gây bệnh, đồng thời đánh giá mức độ nhạy cảm của kháng sinh với vi khuẩn gây bệnh. Việc này sẽ giúp các bác sĩ lựa chọn được loại kháng sinh tốt nhất, từ đó đưa ra phác đồ điều trị phù hợp với cơ thể.
Ngoài ra, thực hiện kháng sinh đồ cũng giúp tổng hợp thông tin dịch tễ học về sự đề kháng của vi khuẩn gây bệnh quan trọng với kháng sinh hiện có, từ đó đưa ra hướng dẫn sử dụng kháng sinh trong điều trị.
Kháng sinh đồ giúp ngăn chặn sự gia tăng của các chủng vi khuẩn, vì vậy khi nghi ngờ nhiễm khuẩn, bác sĩ sẽ chỉ định bệnh nhân thực hiện xét nghiệm.
Phương pháp kháng sinh đồ phổ biến
Lấy mẫu bệnh phẩm là phương pháp phổ biến đang được thực hiện tại nhiều bệnh viện tại Việt Nam. Thông thường chúng sẽ được lấy ở những vị trí cơ quan mà vi khuẩn phát triển và gây nên tình trạng nhiễm khuẩn như: máy, nước tiểu, đờm, dịch mũi, dịch hầu họng,…
Có nhiều phương pháp kháng sinh đồ như:
- Phương pháp định lượng tìm MIC, pha loãng kháng sinh trong thạch hoặc canh thang nhằm xác định được nồng độ tối thiểu của kháng sinh ức chế vi khuẩn
- Phương pháp định tính khoanh giấy kháng sinh khuếch tán trong thạch thường được áp dụng để xác định độ nhạy cảm của vi khuẩn với những phương pháp kháng sinh khác nhau
- Phương pháp phát hiện enzyme do vi khuẩn sinh ra có khả năng phá hủy kháng sinh
Với phương pháp khuếch tán kháng sinh trong thạch
Phương pháp khoanh giấy kháng sinh khuếch tán trong thạch là phương pháp đơn giản và phổ biến hơn cả vì chúng rất dễ thực hiện trong các phòng xét nghiệm:
Nhân viên y tế tiến hành lấy mẫu bệnh phẩm rồi nuôi cấy trên đĩa thạch có chứa môi trường dinh dưỡng đặc biệt để nuôi cấy vi khuẩn gây bệnh
Lựa chọn dòng thuần vi khuẩn gây bệnh bằng cách phân lập và định danh
Một lượng vi khuẩn thích hợp được lấy và trải trên đĩa thạch, đặt các đĩa kháng sinh vào đĩa thạch rồi ủ ở nhiệt độ 35 – 37 độ C
Sau từ 24 – 48 giờ, tiến hành đọc kết quả.
- Đường kính ≤ 11mm: Vi khuẩn kháng thuốc kháng sinh
- Đường kính 12 – 15mm: Trung gian
- Đường kính ≥ 16mm: Kháng sinh nhạy với vi khuẩn gây bệnh
Từ kết quả kháng sinh đồ, các bác sĩ sẽ lựa chọn các loại kháng sinh có độ nhạy cao để đưa ra phác đồ điều trị phù hợp nhất.

